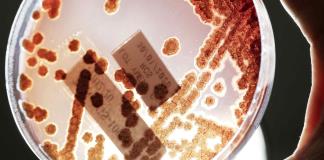

Etiquetas bacterias
Etiqueta: bacterias
Aumentan en Estados Unidos las infecciones por bacterias resistentes a los antibióticos
Miami, Estados Unidos.
Las infecciones por bacterias altamente resistentes a los antibióticos, conocidas como NDM-CRE, se dispararon ...
UDGTV
Radio UdeG